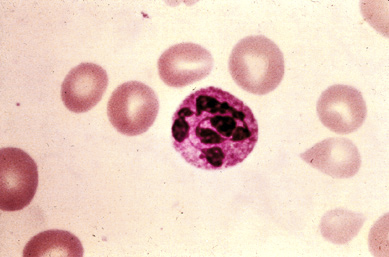
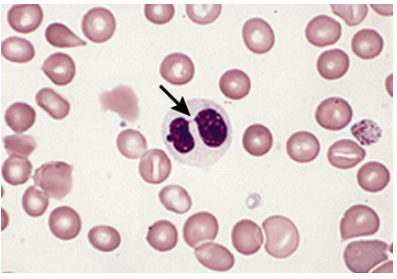

Neutrophil은 3-4개의 lobed neucleus를 가지고 있고 cytoplasm은 pink-sandy, granular 모습입니다.
|
Hypersegmented neutrophil in megaloblastic anemia |
Blood smear from a patient with megaloblastic anemia showing a neutrophil with an increased number of nuclear lobes. At least six discrete lobes are present; normal neutrophils have five lobes or fewer.
|
● Increased lobulation |
Lobulation이 5개보다 많은 것을 hypersegmentation이라 정의하고 megaloblastic process 또는 드물지만 IDA를 시사합니다. IDA에서 hypersegmented neutrophils의 소견은 비타민 B12 결핍이 배제된 IDA 환자 50명을 대상으로 한 연구에서 기술되었습니다. 62 %인 31명에서 hypersegmented neutrophils이 있었습니-다. IDA 소아 환자 94명을 대상으로 한 연구에서 대조군 9%와 비교하여 81%에서 hypersegmented neutrophils이 있었습니다. Grape-like (botryoid) multiple lobulations 또한 heat stroke 환자에서 보일 수 있습니다.
Multilobed neutrophils in a patient with heatstroke and amphetamine use

Heat stroke can cause neutrophils (PMNs) to become multilobed with a grape-like (botyroid) pattern. Panel A shows multilobed PMNs from a patient with heatstroke in the setting of amphetamine use. The white blood cell count was 17,800/microL, and 65 percent of PMNs showed the abnormality. Panel B shows the patient's monocytes, which demonstrate similar changes. Refer to the UpToDate topic on the peripheral blood smear for further information on this and other abnormal neutrophil findings.
|
●Decreased lobulation |
Pelger-Huet anomaly (유전적 질환)에서 발생하거나 MDS 환자에서 후천적 (pseudo-Pelger-Huet)으로 발생할 수 있습니다. 모양은 전형적으로 bilobed nucleus이며 가는 실처럼 서로 연결되어 있는데 "pince-nez" appearance (코안경)입니다.
Decreased nuclear lobes in myelodysplasia (pseudo Pelger-Huet anomaly)
Peripheral blood smear from a patient with refractory anemia with excess blasts (RAEB) shows a neutrophil with a bilobed pseudo-Pelger-Huet (Pelgeroid) nucleus. The two lobes are connected by a thin strand (arrow) giving a "pince-nez" appearance. These nuclei look identical to the those seen in the inherited Pelger-Huet anomaly. This neutrophil also has markedly reduced granulation, a finding commonly seen in the myelodysplastic syndromes.
REF. UpToDate 2020.08.31
'혈액내과 > 조혈' 카테고리의 다른 글
| 진성 적혈구증가증, 에리스로포이에틴, JAK2 변이 [Polycythemia vera, erythropoietin, JAK2 mutations] (0) | 2020.11.02 |
|---|---|
| 다발성 골수종에서 벤스-존스 단백뇨, Bence Jones proteinuria in multiple myeloma (0) | 2020.10.04 |
| 이차성 (반응성) 혈소판증가증, 철결핍성빈혈, Secondary (reactive) thrombocytosis, iron deficiency anemia (0) | 2020.07.04 |
| Iron deficiency anemia, IDA (0) | 2020.06.27 |
| 철분주사제(품명: 베노훼럼주 등) 2020.05.08 (0) | 2020.06.03 |